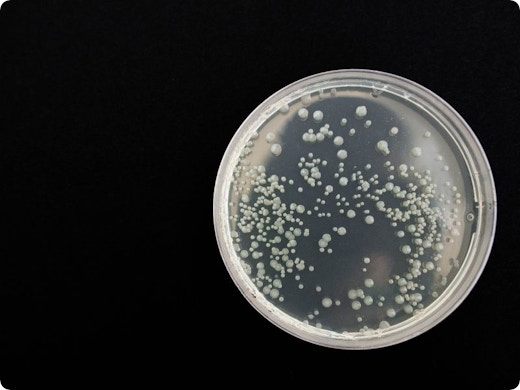
Is jouw ventilatiesysteem broeinest van bacteriën en schimmels? Studie biedt uitsluitsel

Artikels over Luchtkwaliteit
Dit moet je zeker lezen
Meer artikels over Luchtkwaliteit

Volgens experts, zoals Harvard-professor Joseph Allen, zijn ventilatie, daglicht en luchtkwaliteit essentieel om van je huis een gezond huis te maken.
Lees meer
Welke impact heeft de ventilatie van je woning op je gezondheid? Onderzoekers gingen op zoek naar beestjes en schimmels. Maar wat vonden ze uiteindelijk?
Lees meer
Ontdek vier essentiële oplossingen voor het perfecte binnenklimaat. Ontdek slimme ventilatie, strategische zonwering en meer voor optimaal comfort en...
Lees meer
Onze toolbox
Vraag vrijblijvend offertes aan! Ontvang snel max. 4 offertes van vakmannen. Bespaar tijd én geld!
AanvragenMet premies en subsidies kan je flink besparen. Kijk waar jij recht op hebt.
ZoekenMet deze praktische digitale gidsen ben je meteen geïnformeerd en heb je een handige checklist bij de hand.
Aanvragen